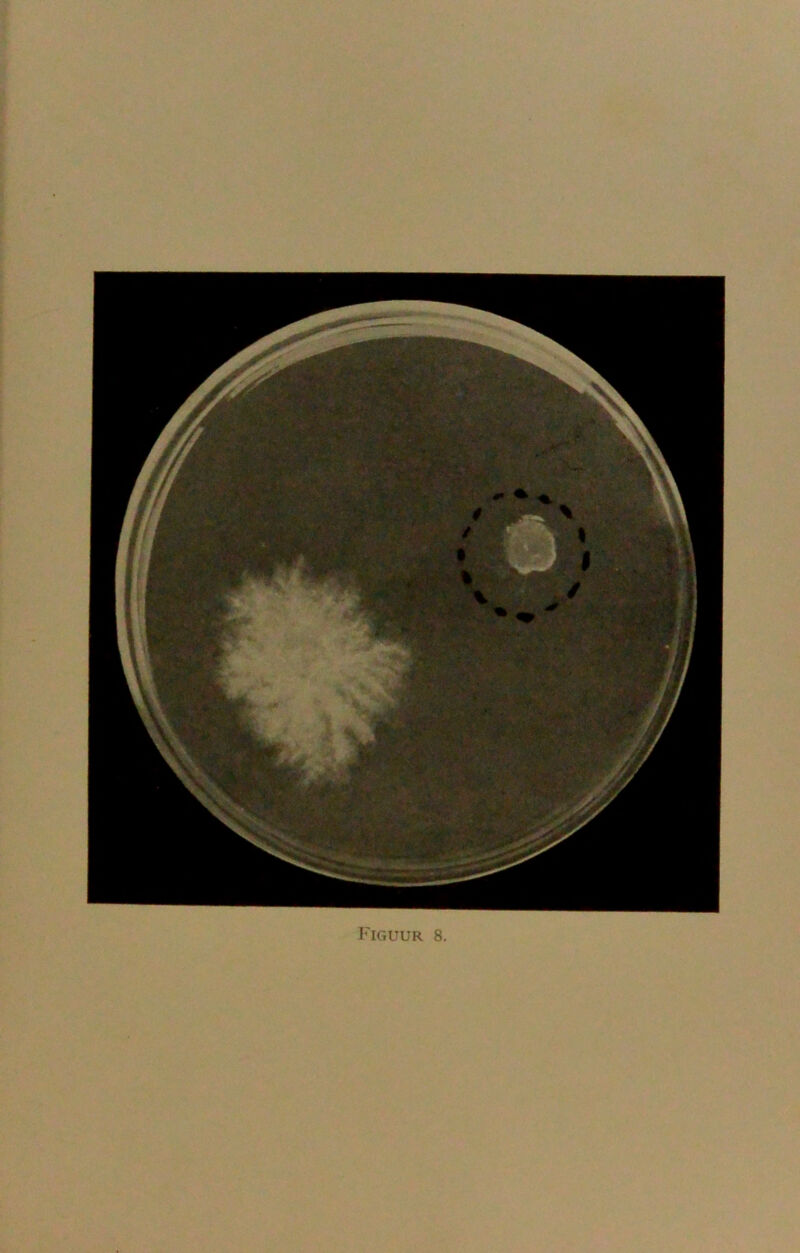
No text description is available for this image

De djamoer oepas-ziekte in het algemeen en bij kina in het bijzonder / door A. Rant.
- Rant, Anton.
- Date:
- 1911
Licence: In copyright
Credit: De djamoer oepas-ziekte in het algemeen en bij kina in het bijzonder / door A. Rant. Source: Wellcome Collection.
55/62